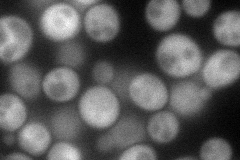
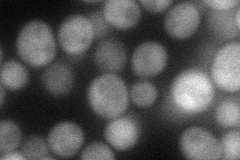
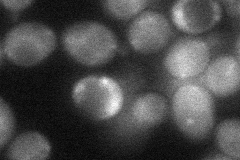
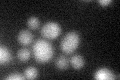

View description
One of three possible beta-subunits of the Snf1 kinase complex, allows nuclear localization of the Snf1 kinase complex in the presence of a nonfermentable carbon source; contains glycogen-binding domain
Localization:
Intensity:
Fold change:
Significance:
-
C’ GFP library in SD

below threshold13.35 -
N' NOP1pr-GFP in SD
cytosol84.3967 -
N' TEF2pr-mCherry in SD
cytosol45.7724 -
N' NATIVEpr-GFP in SD

cytosol54.704 -
N' TEF2pr-VC and Cyto-VN in SD
cytosol35.29 -
C’ GFP library in SD+DTT
cytosolN/AN/ANo -
C’ GFP library in SD+H2O2

cytosolN/AN/ANo -
C’ GFP library in Starvation Media

cytosolN/AN/AYes -
C’ GFP library on the background of Pup2-DaMP

below threshold -
C’ GFP library on the background of CCT mutant

below thresholdN/AN/ANo
